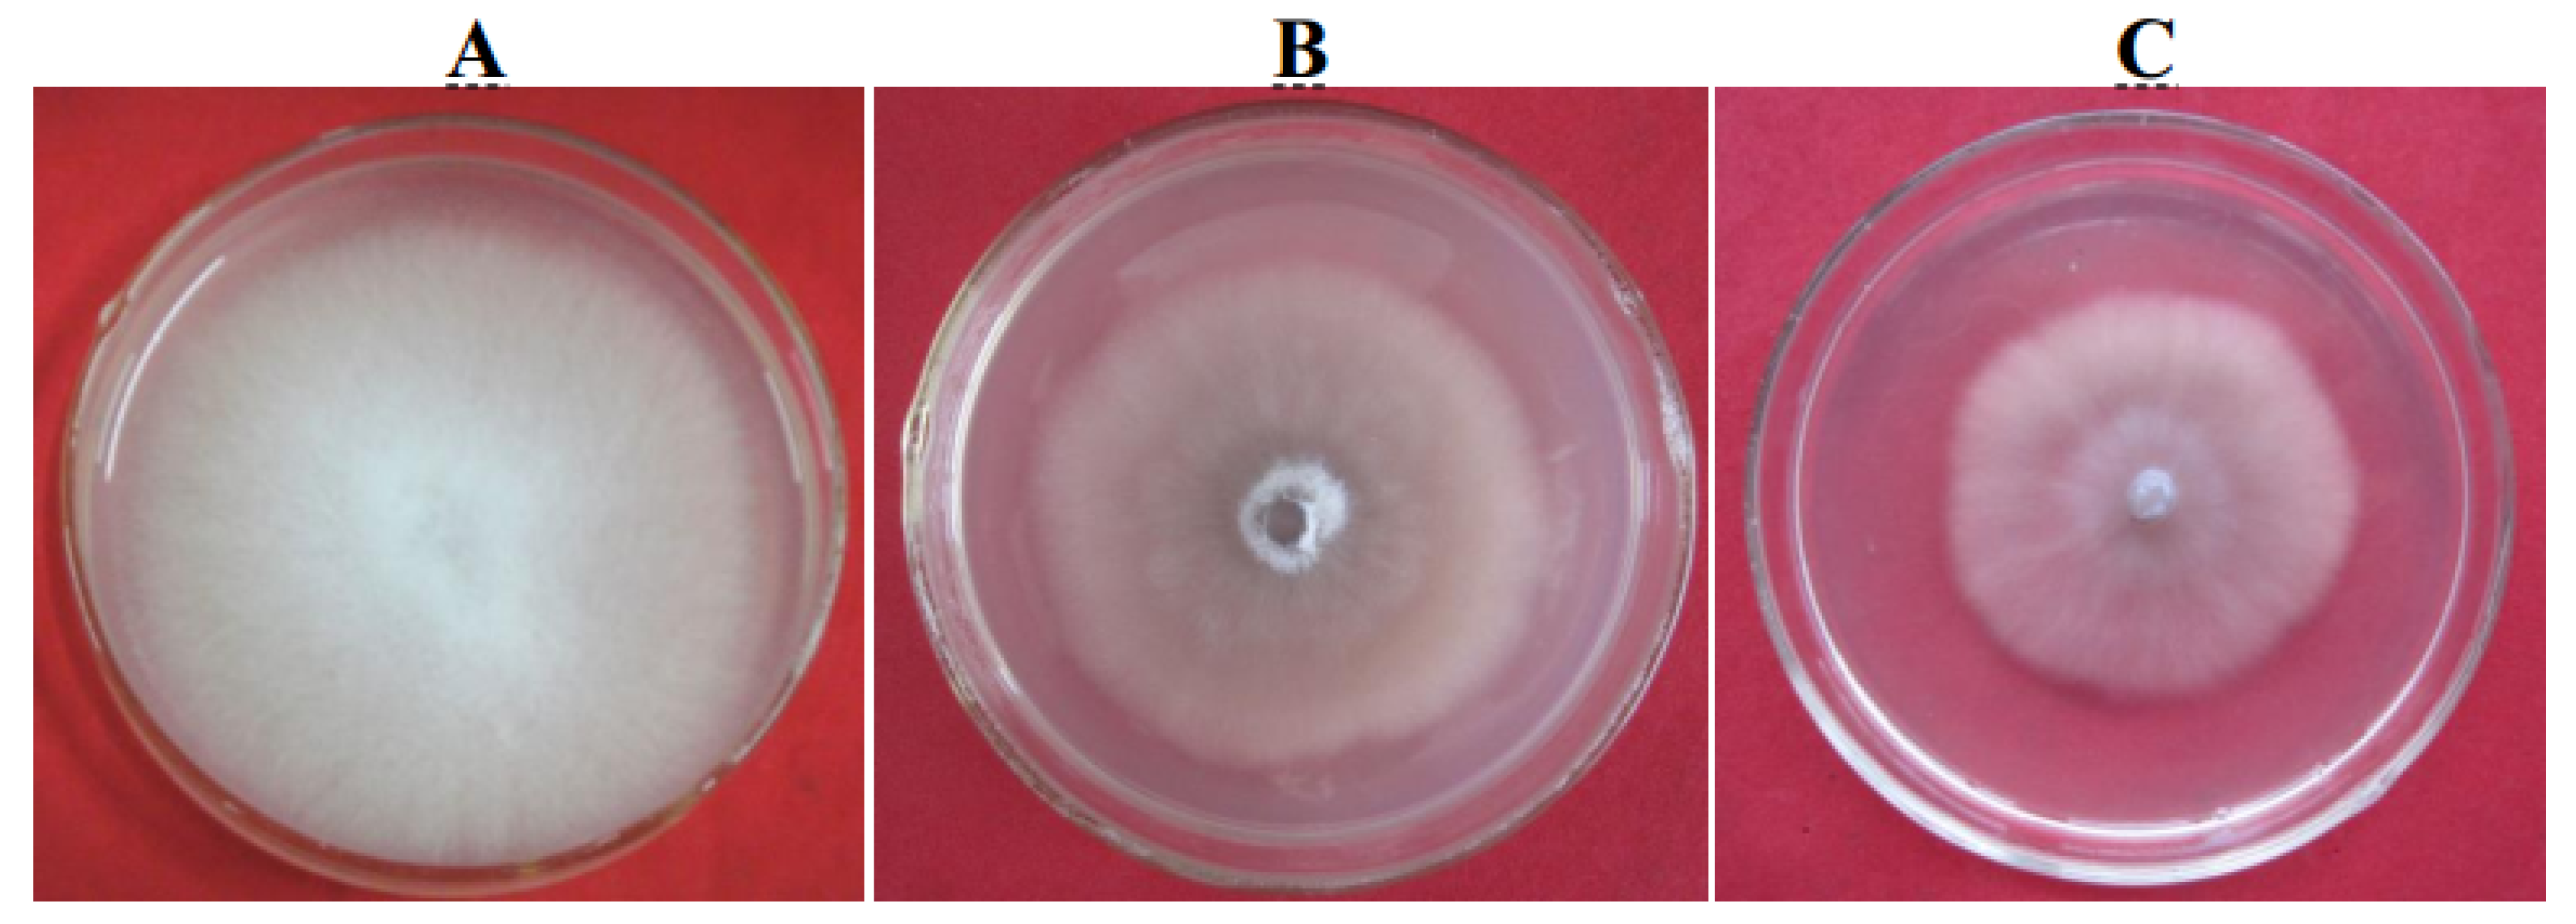
Ijms 21 05886 g007

An Exo-Polygalacturonase Pgc4 Regulates Aerial Hyphal Growth and Virulence in Fusarium oxysporum f. sp. cubense race 4
Abstract
1. Introduction
2. Results
2.1. Purification of Exo-Polygalacturonase Pgc4 from Foc4
2.2. Cloning and Sequence Analysis of the pgc4 from Foc1 and Foc4
2.3. Expression and Purification of Pgc4 From P. Pastoris
2.4. Biochemical Characterization of Recombinant Pgc4
2.5. Active Recombinant Pgc4 Causes Tissue Maceration and Necrosis
2.6. Effect of Mutating Pgc4 on the Foc4 Hyphal Growth
2.7. Role of Foc4 Pgc4 in Foc4 Virulence
3. Discussion
4. Materials and Methods
4.1. Fungal Isolates and Culture Conditions
4.2. PG Activity and Protein Assays
4.3. Isolation and Characterization of Pgc4 from Foc4 Culture Supernatant
4.4. Isolation of Genes Encoding Pgc4 from Foc1 and Foc4
4.5. Expression and Purification of Recombinant Enzymes in P. astoris
4.6. Biochemical Characterization of Pgc4 and r-Pgc4
4.7. Tissue Maceration and Necrosis Assays with r-Pgc4
4.8. Construction of the Foc4 pgc4 Deletion and Complementation Vectors
4.9. Transformation of Foc4
4.10. Pathogenicity Test
5. Conclusions
Author Contributions
Funding
Acknowledgments
Conflicts of Interest
Abbreviations
| Foc4 | Fusarium oxysporum f. sp. cubense race 4 |
| PG | Polygalacturonase |
| PDA | potato dextrose agar |
| SDS–PAGE | sodium dodecyl sulphate–polyacrylamide gel electrophoresis |
| PCR | polymerase chain reaction |
| ORF | open reading frame |
| PGA | Polygalacturonic acid |
References
- Dean, R.; Kan, J.A.L.V.; Pretorius, Z.A.; Hammond-Kosack, K.E.; Di Pietro, A.; Spanu, P.D.; Rudd, J.J.; Dickman, M.; Kahmann, R.; Ellis, J.; et al. The top 10 fungal pathogens in molecular plant pathology. Mol. Plant Pathol. 2012, 13, 414–430. [Google Scholar] [CrossRef] [PubMed]
- Hwang, S.C.; Ko, W.H. Cavendish banana cultivars resistant to Fusarium wilt acquired through somaclonal variation in Taiwan. Plant Dis. 2004, 88, 580–588. [Google Scholar] [CrossRef] [PubMed]
- Ploetz, R.C. Fusarium wilt of banana. Phytopathology 2015, 105, 1512–1521. [Google Scholar] [CrossRef]
- Poon, N.K.; Teo, C.H.; Othman, R.Y. Differential gene expression analysis of secreted in xylem (six) genes from fusarium oxysporum f. sp. cubense tropical race 4 in musa acuminata cv. berangan and potential application for early detection of infection. J. Gen. Plant Pathol. 2020, 86, 13–23. [Google Scholar]
- Grimm, D. Plant genomics. A bunch of trouble. Science 2008, 322, 1046–1047. [Google Scholar] [CrossRef]
- Ploetz, R.C.; Randy, C. Management of Fusarium wilt of banana: A review with special reference to tropical race 4. Crop Prot. 2015, 73, 7–15. [Google Scholar] [CrossRef]
- Guo, L.J.; Yang, L.Y.; Liang, C.C.; Wang, J.; Liu, L.; Huang, J.S. The G-protein subunits FGA2 and FGB1 play distinct roles in development and pathogenicity in the banana fungal pathogen Fusarium oxysporum f. sp. cubense. Physiol. Mol. Plant Pathol. 2016, 93, 29–38. [Google Scholar] [CrossRef]
- Ding, Z.J.; Xu, T.W.; Zhu, W.J.; Li, L.J.; Fu, Q.Y. A MADS-box transcription factor FoRlm1 regulates aerial hyphal growth, oxidative stress, cell wall biosynthesis and virulence in Fusarium oxysporum f. sp. cubense. Fungal Biol. 2020, 124, 183–193. [Google Scholar] [CrossRef]
- Dong, Z.Y.; Wang, Z.Z. Isolation and characterization of an exopolygalacturonase from Fusarium oxysporum f. sp. cubense race 1 and race 4. BMC Biochem. 2011, 12, 51. [Google Scholar]
- Dong, Z.Y.; Wang, Z.Z. Isolation and heterologous expression of a polygalacturonase produced by Fusarium oxysporum f. sp. cubense race 1 and 4. Int. J. Mol. Sci. 2015, 16, 7595–7607. [Google Scholar] [CrossRef]
- Fan, H.Y.; Lei, Z.X.; Dong, H.H.; Zhou, D.B.; Li, H.P. Immune responses in Brazilian banana determining the pathogenic differences between the physiological races 1 and 4 of Fusarium oxysporum f. sp. cubense. J. Plant Pathol. 2018, 101, 225–234. [Google Scholar] [CrossRef]
- Dong, H.H.; Li, Y.F.; Fan, H.Y.; Zhou, D.B.; Li, H.P. Quantitative proteomics analysis reveals resistance differences of banana cultivar ‘Brazilian’ to Fusarium oxysporum f. sp. cubense races 1 and 4. J. Proteom. 2019, 203, 103376. [Google Scholar] [CrossRef] [PubMed]
- Guo, L.J.; Han, L.J.; Yang, L.Y.; Zeng, H.C.; Fan, D.D.; Zhu, Y.B.; Feng, Y.; Wang, G.F.; Peng, C.F.; Jiang, X.T.; et al. Genome and transcriptome analysis of the fungal pathogen Fusarium oxysporum f. sp. cubense causing banana vascular wilt disease. PLoS ONE 2014, 9, e95543. [Google Scholar]
- Yao, C.; Conway, W.S.; Sams, C.E. Purification and characterization of a polygalacturonase produced by Penicillium expansum in apple fruit. Phytopathology 1996, 86, 1160–1166. [Google Scholar] [CrossRef]
- Carrasco, M.; Rozas, J.M.; Alcaíno, J.; Cifuentes, V.; Baeza, M. Pectinase secreted by psychrotolerant fungi: Identification, molecular characterization and heterologous expression of a cold-active polygalacturonase from Tetracladium sp. Microb. Cell Fact. 2019, 18, 45. [Google Scholar] [CrossRef] [PubMed]
- Nakamura, M.; Iwai, H. Functions and mechanisms: Polygalacturonases from plant pathogenic fungi as pathogenicity and virulence factors. J. Gen. Plant Pathol. 2019, 85, 243–250. [Google Scholar] [CrossRef]
- Cervone, F.; Hahn, M.G.; De Lorenzo, G.; Darvill, A.; Albersheim, P. Host-pathogen interactions 1: XXXIII. A plant protein converts a fungal pathogenesis factor into an elicitor of plant defense responses. Plant Physiol. 1989, 90, 542–548. [Google Scholar] [CrossRef]
- Dong, Z.Y.; Wang, Q.; Qin, S.W.; Wang, Z.Z. Comparison of cell wall degrading enzymes produced by Fusarium oxysporum f. sp. cubense race 1 and race 4. Acta Phytopathol. Sin. 2010, 40, 463–468. [Google Scholar]
- Gotesson, A.; Marshall, J.S.; Jones, D.A.; Hardham, A.R. Characterization and evolutionary analysis of a large polygalacturonase gene family in the oomycete plant pathogen Phytophthora cinnamomi. Mol. Plant Microbe Interact. 2002, 15, 907–921. [Google Scholar] [CrossRef]
- Yan, H.Z.; Liou, R.F. Cloning and analysis of pppg1, an inducible endopolygalacturonase gene from the oomycete plant pathogen Phytophthora parasitica. Fungal Genet. Biol. 2005, 42, 339–350. [Google Scholar] [CrossRef]
- Wu, C.H.; Yan, H.Z.; Liu, L.F.; Liou, R.F. Functional characterization of a gene family encoding polygalacturonases in Phytophthora parasitica. Mol. Plant Microbe Interact. 2008, 21, 480–489. [Google Scholar] [CrossRef] [PubMed]
- Bravo Ruiz, G.; Di Pietro, A.; Roncero, M.I.G. Combined action of the major secreted exo- and endopolygalacturonases is required for full virulence of Fusarium oxysporum. Mol. Plant Pathol. 2016, 17, 339–353. [Google Scholar] [CrossRef]
- Esquerré-Tugayé, M.-T.; Boudart, G.; Dumas, B. Cell wall degrading enzymes, inhibitory proteins, and oligosaccharides participate in the molecular dialogue between plants and pathogens. Plant Physiol. Biochem. 2000, 38, 157–163. [Google Scholar] [CrossRef]
- Anand, G.; Yadav, S.; Tanveer, A.; Yadav, D. Purification and Characterization of Microbial Polygalacturonases: An Update. In Advances in Microbial Biotechnology; APH Publishing Corporation: New Delhi, India, 2018. [Google Scholar]
- Anand, G.; Yadav, S.; Yadav, D. Purification and Characterization of Polygalacturonase from Aspergillus fumigatus MTCC 2584 and Elucidating its Application in Retting of Crotalaria juncea Fiber. 3 Biotech 2016, 6, 201. [Google Scholar] [CrossRef] [PubMed]
- de Andrade, M.V.V.; Delatorre, A.B.; Ladeira, S.A.; Martins, M.L.L. Production and Partial Characterization of Alkaline Polygalacturonase Secreted by Thermophilic Bacillus sp. SMIA-2 Under Submerged Culture Using Pectin and Corn Steep Liquor. Ciênc. Tecnol. Aliment. 2011, 31, 204–208. [Google Scholar] [CrossRef]
- Kobayashi, T.; Higaki, N.; Suzumatsu, A.; Sawada, K.; Hagihara, H.; Kawai, S. Purification and properties of a high-molecular-weight, alkaline exopolygalacturonase from a strain of bacillus. Enzyme Microb. Technol. 2001, 29, 70–75. [Google Scholar] [CrossRef]
- Chen, Y.Y.; Sun, D.J.; Zhou, Y.L.; Liu, L.P.; Han, W.W.; Zheng, B.S.; Wang, Z.; Zhang, Z.M. Cloning, Expression and Characterization of a Novel Thermophilic Polygalacturonase from Caldicellulosiruptor bescii DSM 6725. Int. J. Mol. Sci. 2014, 15, 5717–5729. [Google Scholar] [CrossRef]
- Dogan, N.; Tari, C. Characterization of Three Phase Partitioned Exo-Polygalacturonasefrom Aspergillus sojae with Unique Properties. Biochem. Eng. J. 2008, 39, 43–50. [Google Scholar] [CrossRef]
- Tenberge, K. Structure and expression of two polygalacturonase genes of claviceps purpurea oriented in tandem and cytological evidence for pectinolytic enzyme activity during infection of rye. Phytopathology 1996, 86, 1084–1097. [Google Scholar] [CrossRef]
- García-Maceira, F.I.; Di Pietro, A.; Roncero, M.I.G. Cloning and disruption of pgx4 encoding an in planta expressed exopolygalacturonase from Fusarium oxysporum. Mol. Plant Microbe Interact. 2000, 13, 359–365. [Google Scholar] [CrossRef]
- Isshiki, A.; Akimitsu, K.; Yamamoto, M.; Yamamoto, H. Endopolygalacturonase is essential for citrus black rot caused by Alternaria citri but not brown spot caused by Alternaria alternata. Mol. Plant Microbe Interact. 2001, 14, 749–757. [Google Scholar] [CrossRef] [PubMed]
- Chen, X.J.; Li, L.L.; Zhang, Y.; Zhang, J.H.; Ouyang, S.Q.; Zhang, Q.X.; Tong, Y.H.; Xu, J.Y.; Zuo, S.M. Functional analysis of polygalacturonase gene rspg2 from Rhizoctonia solani, the pathogen of rice sheath blight. Eur. J. Plant Pathol. 2017, 149, 491–502. [Google Scholar] [CrossRef]
- Hou, Z.M.; Xue, C.Y.; Peng, Y.L.; Katan, T.; Kistler, H.C.; Xu, J.R. A mitogen-activated protein kinase gene (mgv1) in Fusarium graminearum is required for female fertility, heterokaryon formation and plant infection. Mol. Plant Microbe Interact. 2002, 15, 1119. [Google Scholar] [CrossRef] [PubMed]
- Ding, Z.J.; Li, M.H.; Sun, F.; Xi, P.G.; Sun, L.H.; Zhang, L.H.; Jiang, Z.D. Mitogen-activated protein kinases are associated with the regulation of physiological traits and virulence in Fusarium oxysporum f. sp. cubense. PLoS ONE 2015, 10, e0122634. [Google Scholar] [CrossRef] [PubMed]
- Nakamura, M.; Iwai, H.; Arai, K. Polygalacturonase S31PG1 from Geotrichum candidum citrus race S31 expressed in Schizosaccharomyces pombe versus S31PG2 regarding soft rot on lemon fruit. J. Gen. Plant Pathol. 2003, 69, 283–291. [Google Scholar] [CrossRef]
- Zhang, T.Y.; Sun, X.P.; Xu, Q.; Candelas, L.G.; Li, H.Y. The pH signaling transcription factor PacC is required for full virulence in Penicillium digitatum. Appl. Microbiol. Biotechnol. 2013, 97, 9087–9098. [Google Scholar] [CrossRef]
- Di Pietro, A.; Roncero, M. Endopolygalacturonase from Fusarium oxysporum f. sp. lycopersici: Purification, characterization, and production during infection of tomato plants. Phytopathology 1996, 86, 1324–1330. [Google Scholar]
- Somogyi, M. Note on sugar determination. J. Biol. Chem. 1952, 195, 19–23. [Google Scholar]

| Step | Total Protein (mg) | Total Activity (U) | Yield (% Activity) | Specific Activity (U/mg) |
|---|---|---|---|---|
| Crude | 36.60 | 131.25 | 100 | 3.59 |
| Ultrafiltration | 8.21 | 70.26 | 53.53 | 8.56 |
| Sephacryl S-100 | 1.85 | 26.35 | 20.08 | 14.24 |
| Sepharose FF CM | 0.12 | 3.08 | 2.35 | 25.67 |
| Strain | Disease Statistics | |
|---|---|---|
| Disease Incidence (%) | Disease Index | |
| Water Control | 0 | 0 c* |
| Foc4Δpgc4 | 100 | 15.63 ± 0.27 b |
| Foc4Δpgc4+pgc4 | 100 | 90.17 ± 0.61 a |
| WT | 100 | 89.15 ± 0.32 a |
© 2020 by the authors. Licensee MDPI, Basel, Switzerland. This article is an open access article distributed under the terms and conditions of the Creative Commons Attribution (CC BY) license (http://creativecommons.org/licenses/by/4.0/).
Share and Cite
Dong, Z.; Luo, M.; Wang, Z. An Exo-Polygalacturonase Pgc4 Regulates Aerial Hyphal Growth and Virulence in Fusarium oxysporum f. sp. cubense race 4. Int. J. Mol. Sci. 2020, 21, 5886. https://doi.org/10.3390/ijms21165886
Dong Z, Luo M, Wang Z. An Exo-Polygalacturonase Pgc4 Regulates Aerial Hyphal Growth and Virulence in Fusarium oxysporum f. sp. cubense race 4. International Journal of Molecular Sciences. 2020; 21(16):5886. https://doi.org/10.3390/ijms21165886
Chicago/Turabian StyleDong, Zhangyong, Mei Luo, and Zhenzhong Wang. 2020. "An Exo-Polygalacturonase Pgc4 Regulates Aerial Hyphal Growth and Virulence in Fusarium oxysporum f. sp. cubense race 4" International Journal of Molecular Sciences 21, no. 16: 5886. https://doi.org/10.3390/ijms21165886
APA StyleDong, Z., Luo, M., & Wang, Z. (2020). An Exo-Polygalacturonase Pgc4 Regulates Aerial Hyphal Growth and Virulence in Fusarium oxysporum f. sp. cubense race 4. International Journal of Molecular Sciences, 21(16), 5886. https://doi.org/10.3390/ijms21165886

